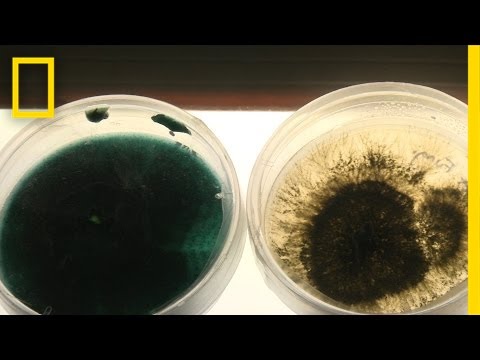

Viewing Channel: National Geographic
Can You Name This African River? (Final Question, 2015 Nat Geo Bee)
From National Geographic
Thu. 05-14-2015
Can You Answer These 3 Geography Questions? | National Geographic
From National Geographic
Thu. 05-14-2015
Untamed River, Part 3: Crime, Mosquitoes, and Monsoons - Nat Geo Live
From National Geographic
Wed. 05-13-2015
Shooters, Showers & Shockwaves | Street Genius (FULL EPISODE)
From National Geographic
Wed. 05-13-2015
Untamed River, Part 2: Death and Beauty in Mongolia - Nat Geo Live
From National Geographic
Tue. 05-12-2015
Untamed River, Part 1: The 2,700-Mile Journey Begins - Nat Geo Live
From National Geographic
Mon. 05-11-2015